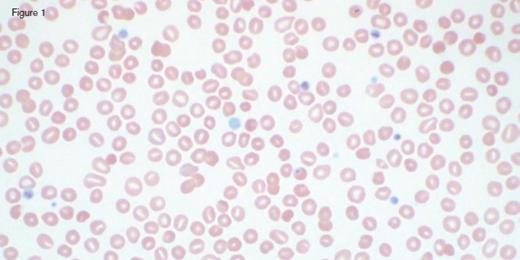
IC Dietrich 3/3/17. / IC Dietrich 3/3/17
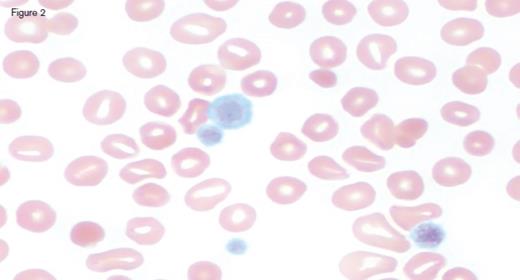
IC Dietrich 3/3/17 Fig 2. / IC Dietrich 3/3/17 Fig 2
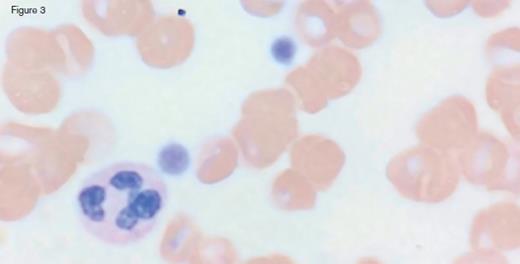
IC Dietrich 3/3/17 Fig 3. / IC Dietrich 3/3/17 Fig 3

A 31-year-old otherwise healthy man was referred to hematology clinic for evaluation of long-standing thrombocytopenia. He has had thrombocytopenia since his teenage years with a platelet count in the 60 to 90 x 109/L range. He had no history of prior bleeding episodes, and had never required therapy for his cytopenia. The remainder of his CBC showed a normal white blood cell count (4.4 x 109/L) and mild anemia (hemoglobin of 11.2 g/dL; MCV of 97.0 fL). The reticulocyte count was 4.45 percent with an absolute count of 158.1 x 109/L. The peripheral blood smear is shown in the images below:
IC Dietrich 3/3/17
IC Dietrich 3/3/17 Fig 2
IC Dietrich 3/3/17 Fig 3
A. Immune thrombocytopenia purpura
B. May-Hegglin Anomaly
C. Phytosterolemia
D. Wiskott-Aldrich syndrome
Sorry, that was not the preferred response.
Correct!
Peripheral blood smear analysis was key in the evaluation of this case. The peripheral blood smear showed stomatocytosis as well as macrothrombocytopenia, raising the possibility of an inherited macrothrombocytopenia disorder. It should be noted that stomatocytes can often be an artifact on blood smears, and therefore must be confirmed by a wet preparation.
Sitosterolemia (also known as phytosterolemia) is a rare inherited sterol storage disorder, resulting in abnormal intestinal absorption of cholesterol and plant sterols. Mutations in ABCG5 and ABCG8 genes, which encode sterolin-1 and sterolin-2, respectively, have been found to be causative for sitosterolemia. Inheritance is autosomal recessive. These genes play an important role in limiting intestinal absorption and promoting biliary excretion of sterols. When mutated, plasma concentrations of plant sterols accumulate and can typically reach 30 to 100 times the upper limit of normal, with mild to moderate elevations in plasma cholesterol. This leads to the clinical manifestations of the disorder, including premature atherosclerosis, xanthoma formation, cardiovascular complications, arthralgias, and hematologic abnormalities including macrothrombocytopenia and hemolytic anemia. In series of families with known mutations, there is phenotypic variation in the clinical manifestations, with some presenting with hematologic features alone.
Given peripheral stomatocytosis, Mediterranean phytosterolemia (sitosterolemia) was considered in this case. Testing of plasma sterols by gas chromatography/mass spectrometry revealed significant elevations in campesterol (159.4 mg/L; normal 0.0-7.0) and sitosterol (387.3 mg/L; normal 0.0-5.0). Next generation sequencing showed a heterozygous C. 1083G > A variant in the ABCG8 gene, which has previously been reported to be a mutation associated with sitosterolemia. Management is with a diet low in plant sterols, which has been effective in causing xanthoma regression and improvement in peripheral cytopenias. Classically, bile acid sequestrants have also been used, and more recently Ezetimibe (which inhibits cholesterol absorption in the small intestine via Niemann-Pick C1-Like1, a sterol transporter) have been initiated as primary preventive strategies to manage the cardiovascular complications of the disorder.
Patients with sitosterolemia are frequently misdiagnosed with immune thrombocytopenia (ITP) secondary to arthritis, or Evans syndrome. In one small series, there was a 28-year delay between symptom onset and the time to correct diagnosis, with some patients receiving inappropriate treatment, including higher risk interventions such as splenectomy. Anemia and stomatocytosis are not observed in ITP.
May-Hegglin Anomaly is a macrothrombocytopenia disorder characterized by mild to moderate thrombocytopenia, giant platelets, and Döhle-like leukocyte inclusion bodies. The disorder was first described by the German physician Richard May, in 1909, and later by the Swiss physician Hegglin in 1945. It is inherited in an autosomal dominant fashion. Bleeding phenotypes may be present and vary from mild to moderate severity, typically following minor procedures. Most patients are asymptomatic. The disease is linked to mutations in the MYH9 gene, which encodes nonmuscle myosin heavy-chain, class IIA. Other MYH9-related disorders include Fechtner syndrome, Sebastian syndrome, and Epstein syndrome, which can also cause congenital macrothrombocytopenia.
Wiskott-Aldrich is an X-linked recessive disorder, with hallmark features of immunodeficiency, platelet dysfunction, eczema, and microthrombocytes (not macrothrombocytes, as in this case). Affected patients frequently present with childhood bleeding. Lymphadenopathy and hepatosplenomegaly may be present. Autoimmune conditions and lymphoid malignancies may also occur in patients with classic WAS, and are a frequent cause of early mortality. Mutations in the WAS gene on the X chromosome are responsible for the disease manifestations.
References
References
The authors indicated no relevant conflicts of interest.